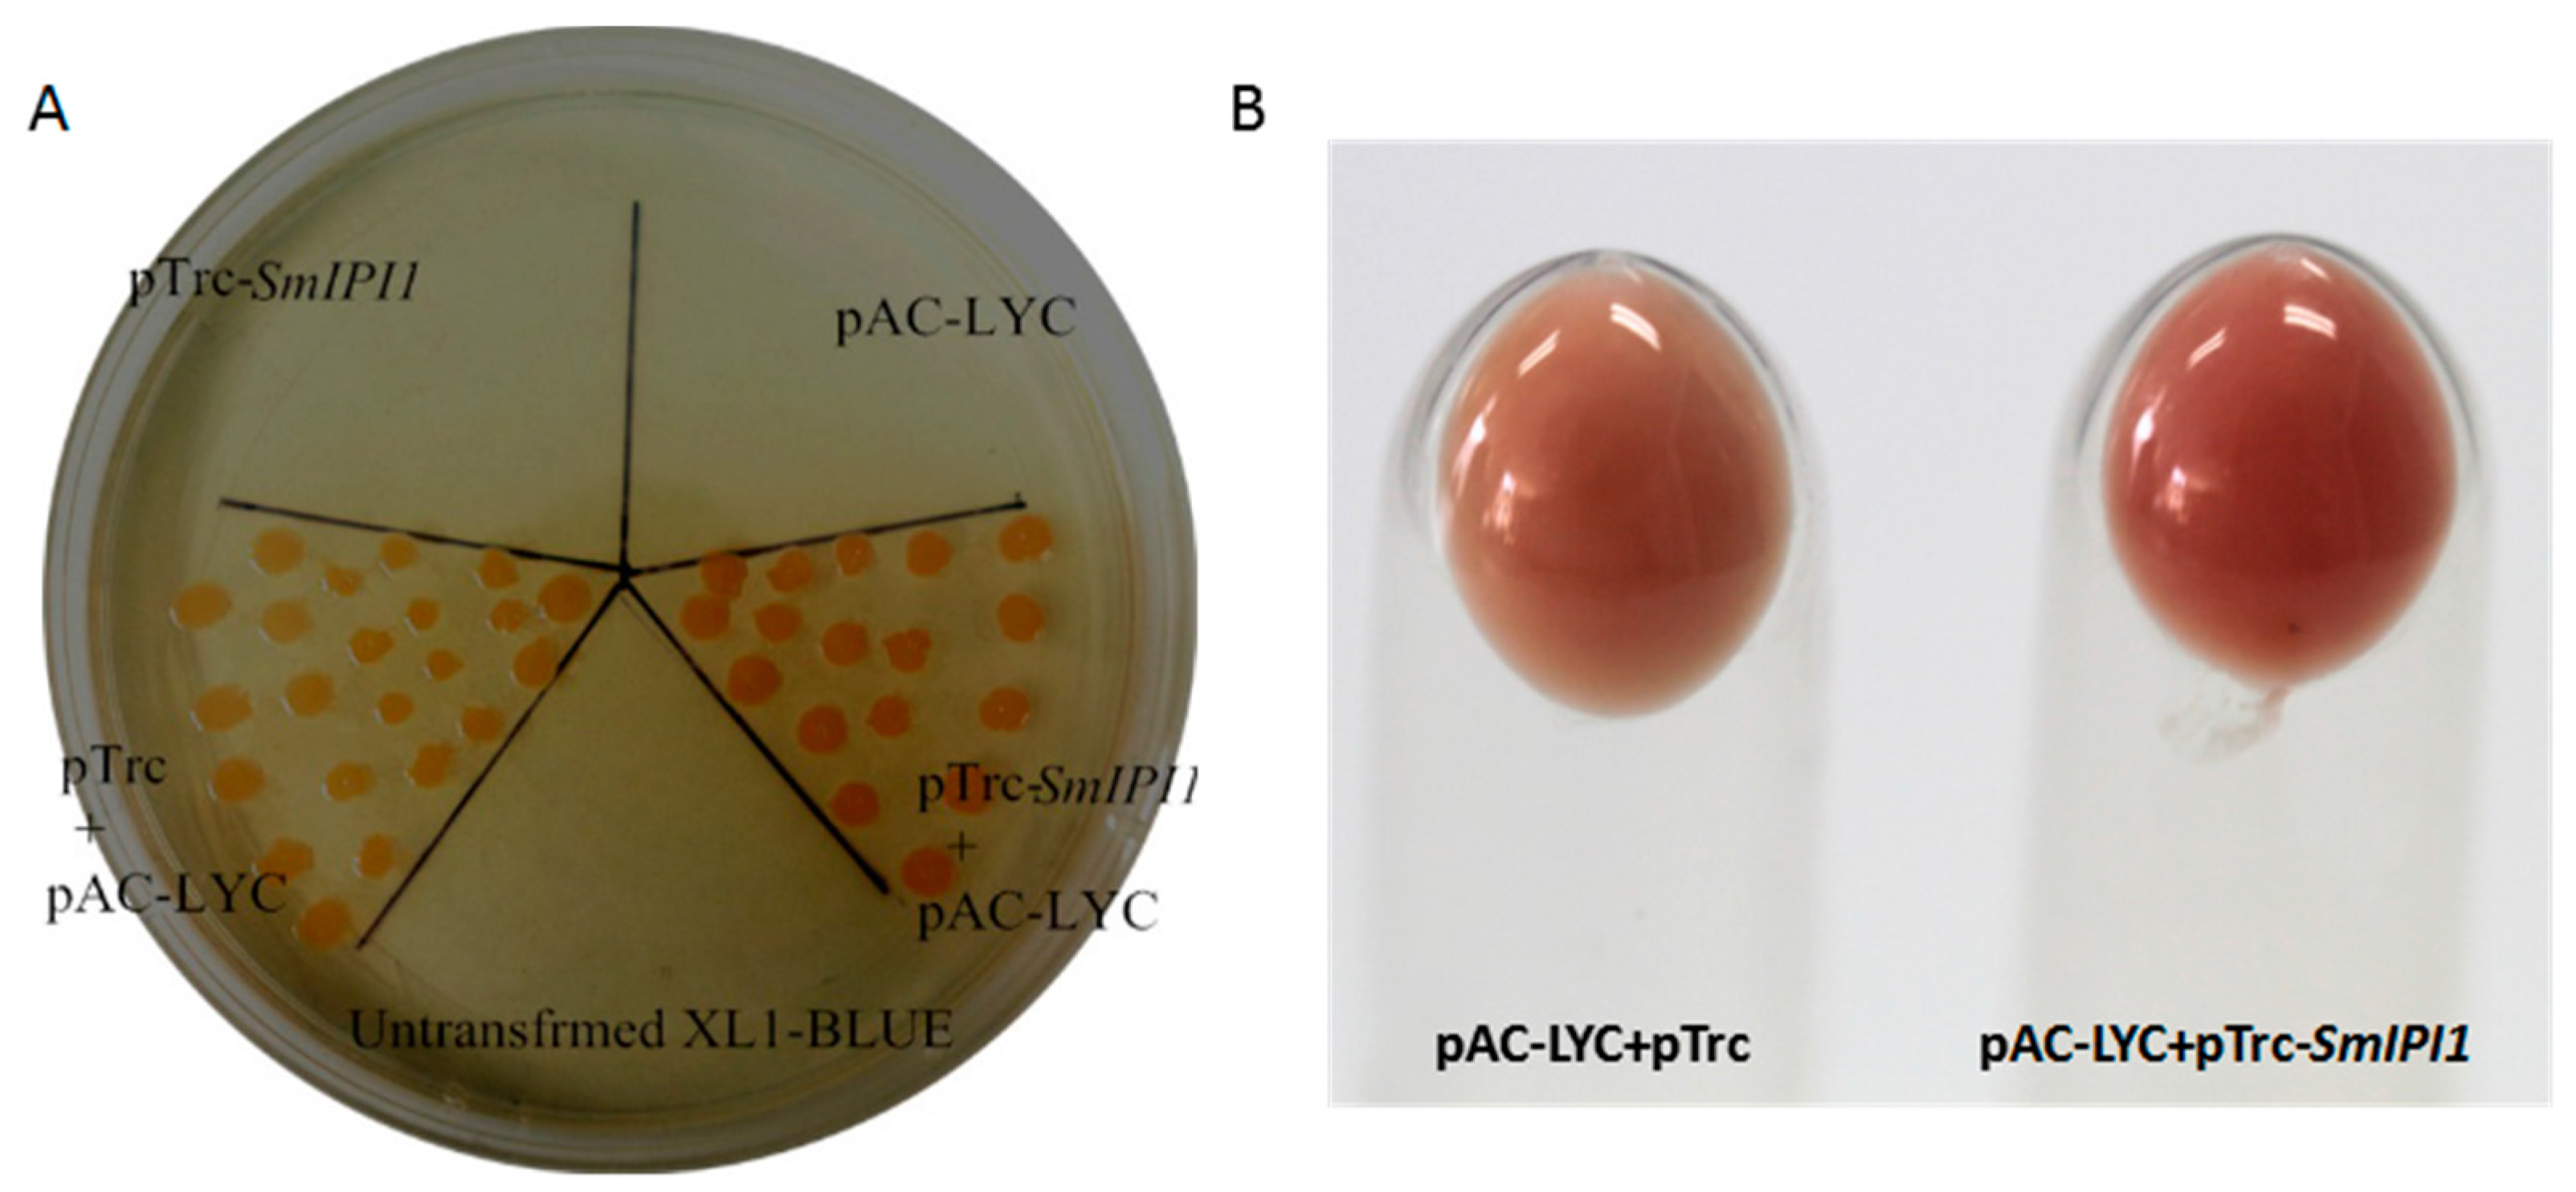
Molecules 20 19689 g005

Functional Analysis of the Isopentenyl Diphosphate Isomerase of Salvia miltiorrhiza via Color Complementation and RNA Interference
Abstract
:1. Introduction

2. Results
2.1. Sequence Analysis of SmIPI cDNA



2.2. mRNA Expression Analysis of SmIPI1 in Different Organs

2.3. Color Complementation Analysis of the SmIPI1 Gene
2.4. Confirmation of Transgenic Plants by Fluorescent Microscopy and PCR Analysis

2.5. Phenotype, mRNA Expression, and Terpenoid Metabolites Content of RNAi Hairy Roots


| Lines | Metabolite contents (mg/g DW) | |||
|---|---|---|---|---|
| Dihydrotanshinone I | Cryptotanshinone | Tanshinone I | Tanshinone IIA | |
| RSi1 | nd | nd | nd | nd |
| RSi2 | nd | nd | nd | nd |
| RSi3 | 0.24 ± 0.13 a | 0.37 ± 0.28 a | 0.56 ± 0.05 a | 0.51 ± 0.14 a |
| RSi4 | nd | nd | nd | nd |
| WT | 7.52 ± 0.97c | 3.52 ± 0.27 b | 2.13 ± 0.12 b | 2.38 ± 0.24 b |
3. Materials and Methods
3.1. Materials
3.2. DNA and RNA Isolation
3.3. Bioinformatics Analysis
3.4. Quantitative Reverse Transcription-Polymerase Chain Reaction (qRT-PCR) Analysis of SmIPI1 Expression Level
3.5. Reconstruction of the Prokaryotic Expression Vector for Functional Identification of Smipi1 through Color Complementation Analysis
3.6. Construction of Interfering Plasmids

3.7. Agrobacterium rhizogenes ACCC 10060 Mediated Gene Transformation into S. miltiorrhiza Hairy Roots
3.8. Green Fluorescent Protein Detection and PCR Verification
3.9. Measurement of Tanshinones Content
4. Discussion
5. Conclusions
Acknowledgments
Author Contributions
Conflicts of Interest
References
- Xu, Z. Modernization: One step at a time. Nature 2011, 480, S90–S92. [Google Scholar] [CrossRef] [PubMed]
- Ren, D.; Du, G.; Zhang, J. Protective effect of total salvianolic acid against cerebral ischemia reperfusion injury. Chin. Pharmacol. Bull. 2002, 18, 219–221. [Google Scholar]
- Tian, P. Convergence: Where West meets East. Nature 2011, 480, S84–S86. [Google Scholar] [CrossRef] [PubMed]
- Koyama, T.; Ogura, K. Comprehensive Natural Product Chemistry; Cane, D.E., Ed.; Elsevier Science Ltd.: Oxford, UK, 1999; pp. 69–96. [Google Scholar]
- Kaneda, K.; Kuzuyama, T.; Takagi, M.; Hayakawa, Y.; Seto, H. An unusual isopentenyl diphosphate isomerase found in the mevalonate pathway gene cluster from Streptomyces sp. strain CL190. Proc. Natl. Acad. Sci. USA 2001, 98, 932–937. [Google Scholar] [CrossRef] [PubMed]
- Takagi, M.; Kaneda, K.; Shimizu, T.; Hayakawa, Y.; Seto, H.; Kuzuyama, T. Bacillus subtilis ypgA gene is fni, a nonessential gene encoding type 2 isopentenyl diphosphate isomerase. Biosci. Biotechnol. Biochem. 2004, 68, 132–137. [Google Scholar] [CrossRef] [PubMed]
- Barkley, S.J.; Desai, S.B.; Poulter, C.D. Type II isopentenyl diphosphate isomerase from Synechocystis sp. strain PCC 6803. J. Bacteriol. 2004, 186, 8156–8158. [Google Scholar] [CrossRef] [PubMed]
- Okada, K.; Kasahara, H.; Yamaguchi, S.; Kawaide, H.; Kamiya, Y.; Nojiri, H.; Yamane, H. Genetic evidence for the role of isopentenyl diphosphate isomerases in the mevalonate pathway and plant development in Arabidopsis. Plant Cell Physiol. 2008, 49, 604–616. [Google Scholar] [CrossRef] [PubMed]
- Anderson, M.S.; Muehlbacher, M.; Street, I.P.; Proffitt, J.; Poulter, C.D. Isopentenyl diphosphate: Dimethylallyl diphosphate isomerase. An improved purification of the enzyme and isolation of the gene from Saccharomyces cerevisiae. J. Biol. Chem. 1989, 264, 19169–19175. [Google Scholar] [PubMed]
- Hahn, F.M.; Hurlburt, A.P.; Poulter, C.D. Escherichia coli open reading frame 696 is idi, a nonessential gene encoding Isopentenyl Diphosphate Isomerase. J. Bacteriol. 1999, 181, 4499–4504. [Google Scholar] [PubMed]
- Blanc, V.M.; Pichersky, E. Nucleotide sequence of a Clarkia breweri cDNA clone of Ipi1, a gene encoding isopentenyl pyrophosphate isomerase. Plant Physiol. 1995, 108, 855–856. [Google Scholar] [CrossRef] [PubMed]
- Sun, Z.; Cunningham, F.X., Jr.; Gantt, E. Differential expression of two isopentenyl pyrophosphate isomerases and enhanced carotenoid accumulation in a unicellular chlorophyte. Proc. Natl. Acad. Sci. USA 1998, 95, 11482–11488. [Google Scholar] [CrossRef] [PubMed]
- Yoon, S.H.; Lee, Y.M.; Kim, J.E.; Lee, S.H.; Lee, J.H.; Kim, J.Y.; Jung, K.H.; Shin, Y.C.; Keasling, J.D.; Kim, S.W. Enhanced lycopene production in Escherichia coli engineered to synthesize isopentenyl diphosphate and dimethylallyl diphosphate from mevalonate. Biotechnol. Bioeng. 2006, 94, 1025–1032. [Google Scholar] [CrossRef] [PubMed]
- Kajiwara, S.; Fraser, P.D.; Kondo, K. Expression of an exogenous isopentenyl diphosphate isomerase gene enhances isoprenoid biosynthesis in Escherichia coli. Biochem. J. 1997, 324, 421–426. [Google Scholar] [CrossRef] [PubMed]
- Sun, J.; Zhang, Y.Y.; Liu, H.; Zou, Z.; Zhang, C.J.; Zhang, X.H.; Li, H.X.; Ye, Z.B. A novel cytoplasmic isopentenyl diphosphate isomerase gene from tomato (Solanum lycopersicum): Cloning, expression, and color complementation. Plant Mol. Biol. Rep. 2010, 28, 473–480. [Google Scholar] [CrossRef]
- Mayer, M.P.; Hahn, F.M.; Stillman, D.J.; Poulter, C.D. Disruption and mapping of IDI1, the gene for isopentenyl diphosphate isomerase in Saccharomyces cerevisiae. Yeast 1992, 8, 743–748. [Google Scholar] [CrossRef] [PubMed]
- Cui, G.H.; Huang, L.Q.; Tang, X.J.; Zhao, J.X. Candidate genes involved in tanshinone biosynthesis in hairy roots of Salvia miltiorrhiza revealed by cDNA microarray. Mol. Biol. Rep. 2011, 38, 2471–2478. [Google Scholar] [CrossRef] [PubMed]
- Zhang, S.; Liu, Y.; Shen, S.; Liang, Z.; Yang, D. Effects of elicitors on accumulation of phenolic acids and tanshinones in Salvia miltiorrhiza hairy root. China J. Chin. Mater. Med. 2011, 36, 1269–1274. [Google Scholar]
- Cunningham, F.X.; Pogson, B.; Sun, Z.R.; McDonald, K.A.; DellaPenna, D.; Gantt, E. Functional analysis of the beta and epsilon lycopene cyclase enzymes of Arabidopsis reveals a mechanism for control of cyclic carotenoid formation. Plant Cell. 1996, 8, 1613–1626. [Google Scholar] [CrossRef] [PubMed]
- Xu, C.; Shu, Z.; Wang, Y.; Miao, F.; Zhou, L. The accumulation rule of the main medicinal components in different organs of Salvia miltiorrhiza Bunge. and Salvia miltiorrhiza Bunge. f. alba. Lishizhen Med. Mater. Med. Res. 2010, 21, 2129–2132. [Google Scholar]
- Del, S.G.; Manfioletti, G.; Schneider, C. The CTAB-DNA precipitation method: A common miniscale preparation of template DNA from phagemids, phages or plasmids suitable for sequencing. Biotechniques 1989, 7, 514–519. [Google Scholar] [PubMed]
- Cunningham, F.X.; Sun, Z.R.; Chamovitz, D.; Hirschberg, J.; Gantt, E. Molecular structure and enzymatic function of lycopene cyclase from the Cyanobacterium Synechococcus sp strain PCC7942. Plant Cell 1994, 6, 1107–1121. [Google Scholar] [CrossRef] [PubMed]
- Dai, Z.B.; Cui, G.H.; Zhou, S.F.; Zhang, X.N.; Huang, L. Cloning and characterization of a novel 3-hydroxy-3-methylglutaryl coenzyme A reductase gene from Salvia miltiorrhiza involved in diterpenoid tanshinone accumulation. J. Plant Physiol. 2011, 168, 148–157. [Google Scholar] [CrossRef] [PubMed]
- Pan, X.C.; Chen, M.; Liu, Y.; Liao, Z.H. Cloning of Deoxyoxylulose-5-phosphate Synthase Gene from Tomato and Its Color Complemention in E. coli. Acta Hortic. Sin. 2007, 34, 371–376. [Google Scholar]
- Jomaa, H.; Wiesner, J.; Sanderbrand, S. Inhibitors of the nonmevalonate pathway of isoprenoid biosynthesis as antimalarial drugs. Science 1999, 285, 1573–1576. [Google Scholar] [CrossRef] [PubMed]
- Zhang, X.N.; Guo, J.; Shen, Y.; Huang, L.Q. Cloning and expression analysis of a new 3-hydroxy-3-methylglutaryl coenzyme A reductase gene from Salvia miltiorrhiza (SmHMGR3). China J. Chin. Mater. Med. 2012, 37, 2378–2382. [Google Scholar]
- Jiang, L.Z.; Li, G.Z.; Jian, Y.W. Effects of biotic and abiotic elicitors on cell growth and tanshinone accumulation in Salvia miltiorrhiza cell cultures. Appl. Microbiol. Biotechnol. 2010, 87, 137–144. [Google Scholar] [CrossRef] [PubMed]
- Garcia-Asua, G.; Lang, H.P.; Cogdell, R.J. Carotenoid diversity: A modular role for the phytoene desaturase step. Trends Plant Sci. 1998, 3, 445–449. [Google Scholar] [CrossRef]
- Ma, Y.; Yuan, L.; Wu, B.; Li, X.; Chen, S.; Lu, S. Genome-wide identification and characterization of novel genes involved in terpenoid biosynthesis in Salvia miltiorrhiza. J. Exp. Bot. 2012, 63, 2809–2823. [Google Scholar] [CrossRef] [PubMed]
- Nakamura, A.; Shimada, H.; Masuda, T.; Ohta, H.; Takamiya, K. Two distinct isopentenyl diphosphate isomerases in cytosol and plastid are differentially induced by environmental stresses in tobacco. FEBS Lett. 2001, 506, 61–64. [Google Scholar] [CrossRef]
- Phillips, M.A.; D’Auria, J.C.; Gershenzon, J.; Pichersky, E. The Arabidopsis thaliana type I Isopentenyl Diphosphate Isomerases are targeted to multiple subcellular compartments and have overlapping functions in isoprenoid biosynthesis. Plant Cell 2008, 20, 677–696. [Google Scholar] [CrossRef] [PubMed]
- Sample Availability: Samples of the plasmids pAC-LYC, pTrc-AtIPI and pTrc-SmIPI1 are available from the authors.
© 2015 by the authors. Licensee MDPI, Basel, Switzerland. This article is an open access article distributed under the terms and conditions of the Creative Commons by Attribution (CC-BY) license ( http://creativecommons.org/licenses/by/4.0/).
Share and Cite
Zhang, X.; Guan, H.; Dai, Z.; Guo, J.; Shen, Y.; Cui, G.; Gao, W.; Huang, L. Functional Analysis of the Isopentenyl Diphosphate Isomerase of Salvia miltiorrhiza via Color Complementation and RNA Interference. Molecules 2015, 20, 20206-20218. https://doi.org/10.3390/molecules201119689
Zhang X, Guan H, Dai Z, Guo J, Shen Y, Cui G, Gao W, Huang L. Functional Analysis of the Isopentenyl Diphosphate Isomerase of Salvia miltiorrhiza via Color Complementation and RNA Interference. Molecules. 2015; 20(11):20206-20218. https://doi.org/10.3390/molecules201119689
Chicago/Turabian StyleZhang, Xianan, Hongyu Guan, Zhubo Dai, Juan Guo, Ye Shen, Guanghong Cui, Wei Gao, and Luqi Huang. 2015. "Functional Analysis of the Isopentenyl Diphosphate Isomerase of Salvia miltiorrhiza via Color Complementation and RNA Interference" Molecules 20, no. 11: 20206-20218. https://doi.org/10.3390/molecules201119689
APA StyleZhang, X., Guan, H., Dai, Z., Guo, J., Shen, Y., Cui, G., Gao, W., & Huang, L. (2015). Functional Analysis of the Isopentenyl Diphosphate Isomerase of Salvia miltiorrhiza via Color Complementation and RNA Interference. Molecules, 20(11), 20206-20218. https://doi.org/10.3390/molecules201119689
